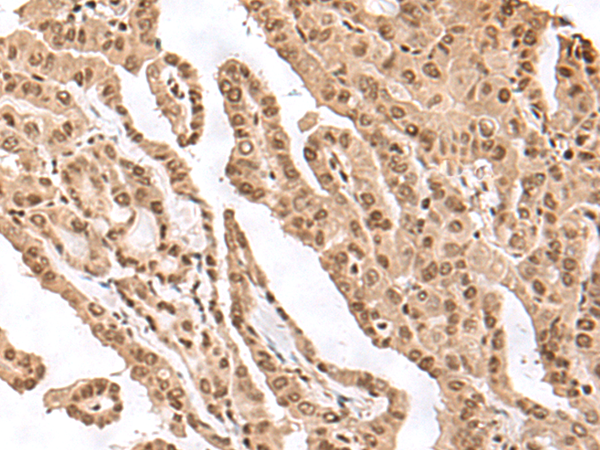

|
Background: |
This gene encodes a component of the human exosome, a exoribonuclease complex which processes and degrades RNA in the nucleus and cytoplasm. This component may play a role in mRNA degradation and the polymyositis/scleroderma autoantigen complex. Alternative splicing results in multiple transcript variants. |
|
Applications: |
ELISA, WB, IHC |
|
Name of antibody: |
EXOSC9 |
|
Immunogen: |
Synthetic peptide of human EXOSC9 |
|
Full name: |
exosome component 9 |
|
Synonyms: |
p5; p6; RRP45; PMSCL1; Rrp45p; PM/Scl-75 |
|
SwissProt: |
Q06265 |
|
ELISA Recommended dilution: |
5000-10000 |
|
IHC positive control: |
Human gastric cancer and Human thyroid cancer |
|
IHC Recommend dilution: |
30-150 |
|
WB Predicted band size: |
49 kDa |
|
WB Positive control: |
HepG2 cell and Human heart tissue lysates |
|
WB Recommended dilution: |
200-1000 |

購(gòu)物車
幫助
021-54845833/15800441009
